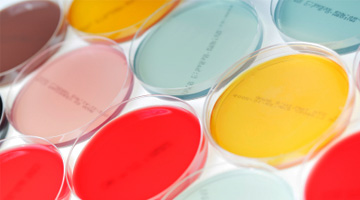

Das Unternehmen wurde für seine Qualität bereits mehrfach prämiert. Die Untenehmensarbeit ist geprägt durch hohe Standards, ständige Entwicklungsarbeit und Qualitätskontrollen. Qualität, Verbraucherschutz und Umweltschutz bilden dabei eine Einheit mit höchster Priorität.